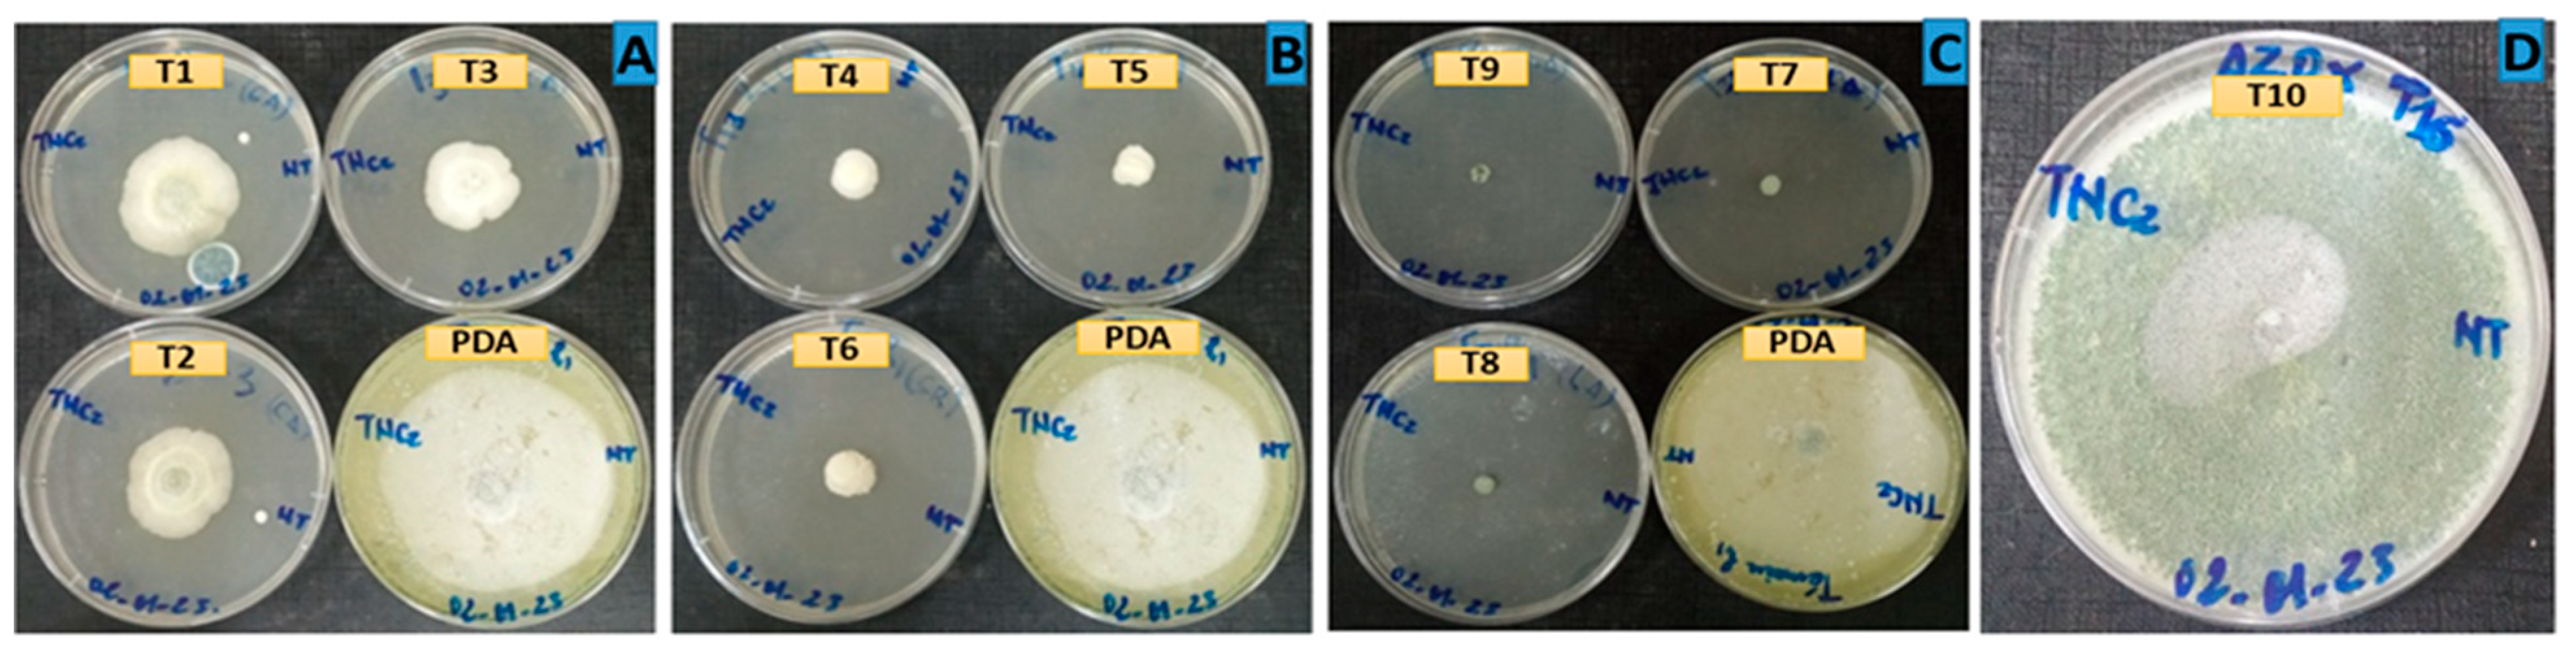
Preprints 88112 g003

Submitted:
18 October 2023
Posted:
19 October 2023
You are already at the latest version
Abstract
Keywords:
1. Introduction
2. Materials and Methods
2.1. Plant material
2.2. Flavus strain
2.3. Extraction of essential oils
2.4. Chemical compositions
2.5. Treatments and incubation
2.6. Parameters assessed and assessment methods
2.7. Statistical analyses
3. Results and discussion
3.1. Chemical composition of essential oils
3.2. Antifungal activity of essential oils
Author Contributions
Acknowledgments
Conflicts of Interest
References
- Manizan, A.L.; Akaki, D.; Piro-Metayer, I.; Montet, D.; Brabet, C.; Koffi-Nevry, R. Évaluation Des Pratiques Post Récolte Favorables à La Contamination de l’arachide Par Les Mycotoxines Dans Trois Régions de Côte d’Ivoire. J. Appl. Biosci. 2018, 124, 12446–12454. [Google Scholar] [CrossRef]
- Guchi, E.; Ayalew, A.; Dejene, M.; Ketema, M.; Asalf, B.; Fininsa, C. Occurrence of Aspergillus Species in Groundnut (Arachis Hypogaea L.) along the Value Chain in Different Agro-Ecological Zones of Eastern Ethiopia. Appl. Environ. Microbiol. 2014, 2, 309–317. [Google Scholar]
- Noba, K.; Ngom, A.; Guèye, M.; Bassène, C.; Kane, M.; Diop, I.; Ndoye, F.; Mbaye, M.S.; Kane, A.; Ba, A.T. L’arachide au Sénégal : état des lieux, contraintes et perspectives pour la relance de la filière. OCL. 2014, 21, D205. [Google Scholar] [CrossRef]
- Schilling, R. Données Agronomiques de Base sur la Culture Arachidière. OCL. 2001, 8, 230–236. [Google Scholar] [CrossRef]
- USDA, F.A.S. World Agricultural Production. Available online: https://apps.fas.usda.gov/PSDOnline/Circulars/2022/12/production.pdf (accessed on 17 May 2023).
- Ajmal, M.; Alshannaq, A.F.; Moon, H.; Choi, D.; Akram, A.; Nayyar, B.G.; Gibbons, J.G.; Yu, J.-H. Characterization of 260 Isolates of Aspergillus Section Flavi Obtained from Sesame Seeds in Punjab, Pakistan. Toxins 2022, 14, 117. [Google Scholar] [CrossRef]
- Dangou, J.M.; Sambo, B.-H.; Moeti, M.; Diarra-Nama, A.-J. Cancer Prevention and Control in the WHO African Region: A Plea for Action. J Afr Cancer. 2009, 1, 56–60. [Google Scholar] [CrossRef]
- Miri, Y.B.; Benabdallah, A.; Taoudiat, A.; Mahdid, M.; Djenane, D.; Tacer-Caba, Z.; Topkaya, C.; Simal-Gandara, J. Potential of Essential Oils for Protection of Couscous against Aspergillus Flavus and Aflatoxin B1 Contamination. Food Control 2023, 145, 109474. [Google Scholar] [CrossRef]
- Cho, H.-J.; Son, S.-H.; Chen, W.; Son, Y.-E.; Lee, I.; Yu, J.-H.; Park, H.-S. Regulation of Conidiogenesis in Aspergillus flavus. Cells 2022, 11, 2796. [Google Scholar] [CrossRef] [PubMed]
- DIOP, Y.; FAYE, A.; SARR, D.; COLY, A.; NGOM, S. Efficacy Test of Melaleuca leucadendra and Callistemon viminalis Essential Oils on in Vitro Control of a Strain of Aspergillus flavus Isolated from Peanut Seeds in Senegal. African Journal of Chemistry 2022, 9, 1–6. [Google Scholar]
- Chen, J.-G.; Egner, P.A.; Ng, D.; Jacobson, L.P.; Muñoz, A.; Zhu, Y.-R.; Qian, G.-S.; Wu, F.; Yuan, J.-M.; Groopman, J.D. Reduced Aflatoxin Exposure Presages Decline in Liver Cancer Mortality in an Endemic Region of China. Cancer Prev Res. 2013, 6, 1038–1045. [Google Scholar] [CrossRef]
- Hu, F.; Tu, X.-F.; Thakur, K.; Hu, F.; Li, X.-L.; Zhang, Y.-S.; Zhang, J.-G.; Wei, Z.-J. Comparison of Antifungal Activity of Essential Oils from Different Plants against Three Fungi. Food Chem Toxicol. 2019, 134, 110821. [Google Scholar] [CrossRef] [PubMed]
- Peles, F.; Sipos, P.; Kovács, S.; Gy\Hori, Z.; Pócsi, I.; Pusztahelyi, T. Biological Control and Mitigation of Aflatoxin Contamination in Commodities. Toxins 2021, 13, 104. [Google Scholar] [CrossRef] [PubMed]
- Pandey, M.K.; Kumar, R.; Pandey, A.K.; Soni, P.; Gangurde, S.S.; Sudini, H.K.; Fountain, J.C.; Liao, B.; Desmae, H.; Okori, P. Mitigating Aflatoxin Contamination in Groundnut through a Combination of Genetic Resistance and Post-Harvest Management Practices. Toxins 2019, 11, 315. [Google Scholar] [CrossRef] [PubMed]
- Bhatnagar-Mathur, P.; Sunkara, S.; Bhatnagar-Panwar, M.; Waliyar, F.; Sharma, K.K. Biotechnological Advances for Combating Aspergillus flavus and Aflatoxin Contamination in Crops. Plant sci. 2015, 234, 119–132. [Google Scholar] [CrossRef] [PubMed]
- Waliyar, F.; Osiru, M.; Ntare, B.R.; Kumar, K.V.K.; Sudini, H.; Traore, A.; Diarra, B. Post-Harvest Management of Aflatoxin Contamination in Groundnut. World Mycotoxin J. 2015, 8, 245–252. [Google Scholar] [CrossRef]
- Udomkun, P.; Wiredu, A.N.; Nagle, M.; Müller, J.; Vanlauwe, B.; Bandyopadhyay, R. Innovative Technologies to Manage Aflatoxins in Foods and Feeds and the Profitability of Application–A Review. Food control 2017, 76, 127–138. [Google Scholar] [CrossRef]
- Hu, Y.; Zhang, J.; Kong, W.; Zhao, G.; Yang, M. Mechanisms of Antifungal and Anti-Aflatoxigenic Properties of Essential Oil Derived from Turmeric (Curcuma longa L. ) on Aspergillus flavus. Food Chem. 2017, 220, 1–8. [Google Scholar] [CrossRef]
- Hou, T.; Sana, S.S.; Li, H.; Xing, Y.; Nanda, A.; Netala, V.R.; Zhang, Z. Essential Oils and Its Antibacterial, Antifungal and Anti-Oxidant Activity Applications: A Review. Food Biosci. 2022, 47, 101716. [Google Scholar] [CrossRef]
- D’agostino, M.; Tesse, N.; Frippiat, J.P.; Machouart, M.; Debourgogne, A. Essential Oils and Their Natural Active Compounds Presenting Antifungal Properties. Molecules 2019, 24, 3713. [Google Scholar] [CrossRef]
- Achar, P.N.; Quyen, P.; Adukwu, E.C.; Sharma, A.; Msimanga, H.Z.; Nagaraja, H.; Sreenivasa, M.Y. Investigation of the Antifungal and Anti-Aflatoxigenic Potential of Plant-Based Essential Oils against Aspergillus flavus in Peanuts. J Fungi. 2020, 6, 383. [Google Scholar] [CrossRef]
- Council of Europe. European Pharmacopoeia, 3rd ed.; Council of Europe: Strasbourg, 1997; ISBN 978-92-871-2991-8. [Google Scholar]
- Joulain, D.; König, W.A. The Atlas of Spectral Data of Sesquiterpene Hydrocarbons; EB-Verlag, 1998; ISBN 3- 930826-48-8.
- Adams, R.P.; others Identification of Essential Oil Components by Gas Chromatography/Mass Spectrometry.; Allured publishing corporation, Carol Stream, IL, 2007.
- NIST (National Institute of Standards and Technology), N. PC Version of the NIST/EPA/NIH Mass Spectra Library. Available online: http://www.nist.gov/srd/nist1a.cfm (accessed on 4 July 2022).
- Zoghbi, M. das G.B.; Andrade, E.H.A.; Oliveira, J.; Carreira, L.M.M.; Guilhon, G.M.S.P. Yield and Chemical Composition of the Essential Oil of the Stems and Rhizomes of Cyperus articulatus L. Cultivated in the State of Pará, Brazil. J. Essent. Oil Res. 2006, 18, 10–12. [CrossRef]
- Nogueira, M.L.; Lima, E.J.S.P. de; Adrião, A.A.X.; Fontes, S.S.; Silva, V.R.; Santos, L. de S.; Soares, M.B.P.; Dias, R.B.; Rocha, C.A.G.; Costa, E.V.; et al. Cyperus articulatus L. (Cyperaceae) Rhizome Essential Oil Causes Cell Cycle Arrest in the G2/M Phase and Cell Death in HepG2 Cells and Inhibits the Development of Tumors in a Xenograft Model. Molecules 2020, 25, 2687. [CrossRef]
- Swain, A.; Duraivadivel, P.; Choudhir, G.; Hariprasad, P. Chemical Composition and Antimicrobial Properties of the Rhizome Essential Oil of Cyperus articulatus L. Grown in Karnataka, India. Indian J Nat Prod Resour. 2022, 13, 112–118. [Google Scholar] [CrossRef]
- Cisse, K.; Gassama, D.; Thiam, A.; Ndiaye, E.H.B.; Gueye, M.T.; Fall, M. Comparative Study of S235 Steel Corrosion Inhibition by Eucalyptus camaldulensis and Cyperus rotundus Essential Oils in Hydrochloric Acid Solution. Am. J. Phys. Chem. 2021, 10, 6–15. [Google Scholar] [CrossRef]
- Ghannadi, A.; Rabbani, M.; Ghaemmaghami, L.; Malekian, N. Phytochemical Screening and Essential Oil Analysis of One of the Persian Sedges; Cyperus rotundus L. IJPSR, 2012, 3, 424. [CrossRef]
- Jirovetz, L.; Wobus, A.; Buchbauer, G.; Shafi, M.P.; Thampi, P.T. Comparative Analysis of the Essential Oil and SPME-Headspace Aroma Compounds of Cyperus rotundus L. Roots/Tubers from South-India Using GC, GC-MS and Olfactometry. J. Essent. Oil-Bear. Plants. 2004, 7, 100–106. [CrossRef]
- Glamočlija, J.; Soković, M.; Tešević, V.; Linde, G.A.; Colauto, N.B. Chemical Characterization of Lippia alba Essential Oil: An Alternative to Control Green Molds. Braz. J. Microbiol. 2011, 42, 1537–1546. [Google Scholar] [CrossRef] [PubMed]
- Tavares, E.S.; Julião, L.S.; Lopes, D.; Bizzo, H.R.; Lage, C.L.S.; Leitão, S.G. Análise Do Óleo Essencial de Folhas de Três Quimiotipos de Lippia Alba (Mill.) NE Br.(Verbenaceae) Cultivados Em Condições Semelhantes. Rev. bras. farmacogn. 2005, 15, 1–5. [Google Scholar] [CrossRef]
- Fischer, U.; Lopez, R.; Pöll, E.; Vetter, S.; Novak, J.; Franz, C.M. Two Chemotypes within Lippia alba Populations in Guatemala. Flavour Fragr. J. 2004, 19, 333–335. [Google Scholar] [CrossRef]
- Kumar, S.; Bahl, J.R.; Bansal, R.P.; Garg, S.N.; Naqvi, A.A.; Khanuja, S.P.S.; Shasany, A.K.; Darokar, M.P.; Singh, V.; Sinha, S. Lippia Alba Plant Named ‘Bhurakshak’ 2002.
- Atti-Serafini, L.; Pansera, M.R.; Atti-Santos, A.C.; Rossato, M.; Pauletti, G.F.; Rota, L.D.; Paroul, N.; Moyna, P. Variation in Essential Oil Yield and Composition of Lippia alba (Mill. NE Br.) Grown in Southern Brazil. Rev. Bras. Pl. Med. 2002, 4, 72–74. [Google Scholar]
- Tucker, A.O.; Madarello, M.J. Volatile Leaf Oil of the “Licorice Verbena”[Lippia alba (Mill.) NE Brown Ex Britton and P. Wils. Var. Carterae Moldenke] from the North American Herb Trade. J. Essent. Oil Res. 1999, 11, 314–316. [Google Scholar] [CrossRef]
- Dellacassa, E.; Menéndez, P.; Moyna, P.; Soler, E. Chemical Composition of Eucalyptus Essential Oils Grown in Uruguay. Flavour Fragr. J. 1990, 5, 91–95. [Google Scholar] [CrossRef]
- Lorenzo, D.; Paz, D.; Davies, P.; Vila, R.; Canigueral, S.; Dellacassa, E. Composition of a New Essential Oil Type of Lippia alba (Mill.) NE Brown from Uruguay. Flavour Fragr. J. 2001, 16, 356–359. [Google Scholar] [CrossRef]
- Pandey, A.K.; Sonker, N.; Singh, P. Efficacy of Some Essential Oils against Aspergillus flavus with Special Reference to Lippia alba Oil an Inhibitor of Fungal Proliferation and Aflatoxin B1 Production in Green Gram Seeds during Storage. J. Food Sci. 2016, 81, M928–M934. [Google Scholar] [CrossRef] [PubMed]
- Shukla, R.; Kumar, A.; Singh, P.; Dubey, N.K. Efficacy of Lippia alba (Mill.) NE Brown Essential Oil and Its Monoterpene Aldehyde Constituents against Fungi Isolated from Some Edible Legume Seeds and Aflatoxin B1 Production. Int. J. Food Microbiol. 2009, 135, 165–170. [CrossRef]
- Mesa-Arango, A.C.; Montiel-Ramos, J.; Zapata, B.; Durán, C.; Betancur-Galvis, L.; Stashenko, E. Citral and Carvone Chemotypes from the Essential Oils of Colombian Lippia alba (Mill.) NE Brown: Composition, Cytotoxicity and Antifungal Activity. Mem. Inst. Oswaldo Cruz. 2009, 104, 878–884. [Google Scholar] [CrossRef] [PubMed]
- Abd El-Kaream, G.F. Role of Cyperus rotundus Oil in Decreasing Hair Growth. J. Complement. Med. Res. 2012, 1, 111–118. [Google Scholar]
- Abo-Altemen, R.A.; Al-Shammari, A.M.; Shawkat, M.S. GC-MS Analysis and Chemical Composition Identification of Cyperus rotundus L. from Iraq. Energy Procedia 2019, 157, 1462–1474. [Google Scholar] [CrossRef]
- Aeganathan, R.; Rayar, A.; Ilayaraja, S.; Prabakaran, K.; Manivannan, R. Anti-Oxidant, Antimicrobial Evaluation and GC-MS Analysis of Cyperus rotundus L. Rhizomes Chloroform Fraction. AJEthno. 2015, 2, 14–20. [Google Scholar]

| Treatment code | Products | Doses (ppm) | Study status |
|---|---|---|---|
| T0 | PDA + ethanol | - | Negative control |
| T1 | EO of C. articulatus | 100 | Tested |
| T2 | 500 | ||
| T3 | 1000 | ||
| T4 | EO of C. rotondus | 100 | |
| T5 | 500 | ||
| T6 | 1000 | ||
| T7 | EO of L. alba | 100 | |
| T8 | 500 | ||
| T9 | 1000 | ||
| T10 | Azoxystrobin | 1000 | Positive control |
| Na | Compounds | lRIb | RIac | RIpd | C. articulatus | C. rotondus | L. alba |
| 1 | α-Pinene | 931 | 931 | 1015 | 0.5 | 0.7 | - |
| 2 | Tuja-2,4(10)diene | 946 | 941 | 1123 | 0.1 | - | - |
| 3 | 6-Methylhept-5-en-2-one | 963 | 963 | 1337 | - | - | 0.5 |
| 4 | β-Pinene | 978 | 972 | 1108 | 0.3 | 0.6 | - |
| 5 | p-Cymene | 1015 | 1013 | 1264 | 0.1 | 0.1 | - |
| 6 | Limonene | 1025 | 1022 | 1200 | 0.1 | 0.4 | 0.7 |
| 7 | (E)-β-Ocimene | 1041 | 1034 | 1247 | - | - | 0.1 |
| 8 | γ-Terpineole | 1051 | 1058 | 1239 | 0.1 | - | - |
| 9 | p-Cymenene | 1075 | 1071 | 1432 | 0.1 | - | - |
| 10 | Linalol | 1086 | 1081 | 1544 | - | - | 0.5 |
| 11 | Nopinone | 1116 | 1108 | 1578 | - | 0.1 | - |
| 12 | α-Camphenal | 1105 | 1109 | 1481 | 0.3 | 0.1 | - |
| Na | Compounds | lRIb | RIac | RIpd | C. articulatus | C. rotondus | L. alba |
| 13 | Trans-pinocarveol | 1126 | 1127 | 1650 | 1.7 | - | - |
| 14 | Citronellal | 1132 | 1131 | 1479 | - | - | 0.1 |
| 15 | Cis-verbenol | 1132 | 1131 | 1655 | - | 0.1 | - |
| 16 | Transverbenone | 1136 | 1131 | 1652 | 0.8 | - | - |
| 17 | Pinocarvone | 1137 | 1141 | 1558 | 0.4 | 0.2 | - |
| 18 | p-Mentha-1,5-dien-8-ol | 1148 | 1149 | 1689 | 0.5 | - | - |
| 19 | Isogeranial | 1156 | 1159 | 1748 | - | - | 1.2 |
| 20 | Terpinen-4-ol | 1164 | 1164 | 1570 | 0.3 | - | - |
| 21 | Myrtenal | 1172 | 1169 | 1628 | 0.8 | 0.6 | - |
| 22 | α-Terpineol | 1177 | 1176 | 1684 | 0.2 | - | - |
| 23 | Myrtenol | 1176 | 1181 | 1789 | 1.8 | - | - |
| 24 | Trans-Dihydrocarvone | 1177 | 1181 | 1626 | - | 0.2 | - |
| 25 | Verbenone | 1183 | 1185 | 1707 | - | 0.3 | - |
| 26 | Cuminaldehyde | 1213 | 1212 | 1782 | - | Tr | - |
| 27 | Transcarveol | 1200 | 1202 | 1824 | - | Tr | - |
| 28 | Carvone | 1214 | 1216 | 1739 | 0.1 | 0.2 | - |
| 29 | Neral | 1215 | 1214 | 1679 | - | - | 34.6 |
| 30 | Geranial | 1244 | 1247 | 1731 | - | - | 46.6 |
| 31 | Geranyl acetate | 1362 | 1361 | 1752 | - | - | 1.3 |
| 32 | Cyperadiene | 1365 | 1363 | 1536 | 0.3 | - | - |
| 33 | α-Ylangene | 1374 | 1371 | 1476 | - | 0.4 | - |
| 34 | α-Copaene | 1379 | 1375 | 1468 | 1.9 | 2.1 | - |
| 35 | β-Elemene | 1389 | 1386 | 1589 | 0.1 | 0.2 | 0.5 |
| 36 | Sativene | 1395 | 1393 | 1529 | - | 0.3 | - |
| 37 | Cyperene | 1402 | 1400 | 1525 | 4.8 | 1.1 | - |
| 38 | Trans-β-Caryophyllene | 1421 | 1417 | 1583 | 0.3 | 0.4 | 4.2 |
| 39 | α-Guaiene | 1440 | 1440 | 1583 | 0.2 | - | 0.9 |
| 40 | Humulene | 1455 | 1450 | 1660 | - | 0.7 | 1.1 |
| 41 | Rotundene | 1461 | 1456 | 1629 | 1.2 | 0.3 | - |
| 42 | Alloaromadendrene | 1462 | 1462 | 1638 | - | 0.3 | - |
| 43 | γ-Muurolene | 1474 | 1470 | 1681 | 0.6 | 1.0 | 0.4 |
| 44 | Germacrene D | 1479 | 1476 | 1704 | 0.6 | Tr | 0.7 |
| 45 | β-Guaiene | 1482 | 1484 | 1719 | - | 0.1 | - |
| 46 | Germacrene A | 1484 | 1485 | 1695 | - | 0.1 | - |
| 47 | α-Bulnesene | 1503 | 1494 | 1711 | 0.2 | 0.4 | 0.5 |
| 48 | Nootkatene | 1512 | 1509 | 1812 | - | 0.2 | - |
| 49 | δ-Cadinene | 1515 | 1510 | 1746 | - | 0.3 | - |
| 50 | Cis-calamenene | 1517 | 1512 | 1816 | 0.5 | - | - |
| 51 | α-Calocorene | 1527 | 1528 | 1895 | 0.7 | 0.3 | - |
| 52 | Trans-α-bisabolene | 1530 | 1532 | 1753 | - | - | 0.1 |
| Na | Compounds | lRIb | RIac | RIpd | C. articulatus | C. rotondus | L. alba |
| 53 | Salvidienol | 1541 | 1540 | 1980 | - | 1.6 | - |
| 54 | β-Calocorene | 1548 | 1548 | 1936 | 0.2 | 0.3 | - |
| 55 | Spathulenol | 1572 | 1560 | 2119 | 0.5 | 1.0 | - |
| 56 | Epiglobulol | 1552 | 1562 | 2037 | - | 0.4 | - |
| 57 | (E)-Nerolidol | 1553 | 1552 | 2027 | 2.3 | - | - |
| 58 | 5-Formyl-5-nor-β-caryophyllene | 1567 | 1569 | 1994 | 0.5 | - | - |
| 59 | Caryophyllene oxide | 1570 | 1573 | 1959 | 5.9 | 25.2 | 2.0 |
| 60 | β-Copaen-4-α-ol | 1572 | 1583 | 2141 | 1.7 | 0.2 | - |
| 61 | 14-Hydroxy-α-muurolene | 1758 | 1585 | 2531 | 1.4 | - | - |
| 62 | β-Oplopenone | 1594 | 1595 | 2052 | - | - | - |
| 63 | Humulene epoxyde 2 | 1602 | 1598 | 2044 | 4.5 | 35.0 | 0.4 |
| 64 | Caryophylla-4(14),8(15)-dien-5α-ol | 1620 | 1628 | 2285 | - | 0.3 | - |
| 65 | Cubenol | 1630 | 1633 | 1998 | 1.1 | - | - |
| 66 | Longiverbenone | 1644 | 1652 | 2230 | - | 4.5 | - |
| 67 | Amorpha-4,7(11)-dien-3-one | 1667 | 1664 | 2245 | - | 3.4 | - |
| 68 | Mustakone | 1669 | 1667 | 2270 | 21.4 | 2.0 | - |
| 69 | Eudesma-4(15)-7-dien-1β-ol | 1672 | 1673 | 1671 | 8.8 | - | - |
| 70 | Cyperotundone | 1671 | 1673 | 2278 | 2.2 | 1.5 | - |
| 71 | Ylangenal | 1675 | 1677 | 2300 | - | 0.6 | - |
| 72 | Cyclocolorenone | 1751 | 1765 | 2348 | - | 0.6 | - |
| 73 | α-Cyperone | 1758 | 1778 | 2358 | - | 0.3 | - |
| 74 | 14-Hydroxy-α-humulene | 1691 | 1690 | 2448 | 2.2 | - | - |
| 75 | Aristolone | 1745 | 1738 | 2396 | 1.3 | - | - |
| Hydrocarbon monoterpenes | 1.2 | 1.8 | 0.8 | ||||
| Oxygenated monoterpenes | 7.0 | 1.8 | 84.3 | ||||
| Hydrocarbon sesquiterpenes | 11.6 | 8.5 | 8.4 | ||||
| Oxygenated sesquiterpenes | 53.8 | 76.6 | 2.4 | ||||
| Other compounds | - | - | 0.5 | ||||
| Total identified (%) | 73.6 | 88.7 | 96.4 | ||||
| Yields (w/w vs dry material) | 1.1 | 1.3 | 1.7 | ||||
|
a Order of elution is given on apolar column (Rtx-1). b Retention indices of literature on the apolar column (lRIa). c Retention indices on the apolar Rtx-1 column (RIa). d Retention indices on the polar Rtx-Wax column (RIp). |
|||||||
| Species | Doses (ppm) | Inhibition of mycelial growth | |
|---|---|---|---|
| Inhibition rate (%) 1 | Average diameter (cm) 1 | ||
| C. articulatus | T1 (100) | 75.08 | 3.10 |
| T2 (500) | 76.65 | 3.01 | |
| T3 (1000) | 78.11 | 2.83 | |
| C. rotundus | T4 (100) | 83.79 | 1.58 |
| T5 (500) | 85.00 | 1.33 | |
| T6 (1000) | 93.65 | 1.28 | |
| L. alba | T7 (100 ) | 100 | 0.00 |
| T8 (500) | 100 | 0.00 | |
| T9 (1000) | 100 | 0.00 | |
| Azoxystrobin | T10 (1000) | 34.30 | 8.20 |
Disclaimer/Publisher’s Note: The statements, opinions and data contained in all publications are solely those of the individual author(s) and contributor(s) and not of MDPI and/or the editor(s). MDPI and/or the editor(s) disclaim responsibility for any injury to people or property resulting from any ideas, methods, instructions or products referred to in the content. |
© 2023 by the authors. Licensee MDPI, Basel, Switzerland. This article is an open access article distributed under the terms and conditions of the Creative Commons Attribution (CC BY) license (http://creativecommons.org/licenses/by/4.0/).